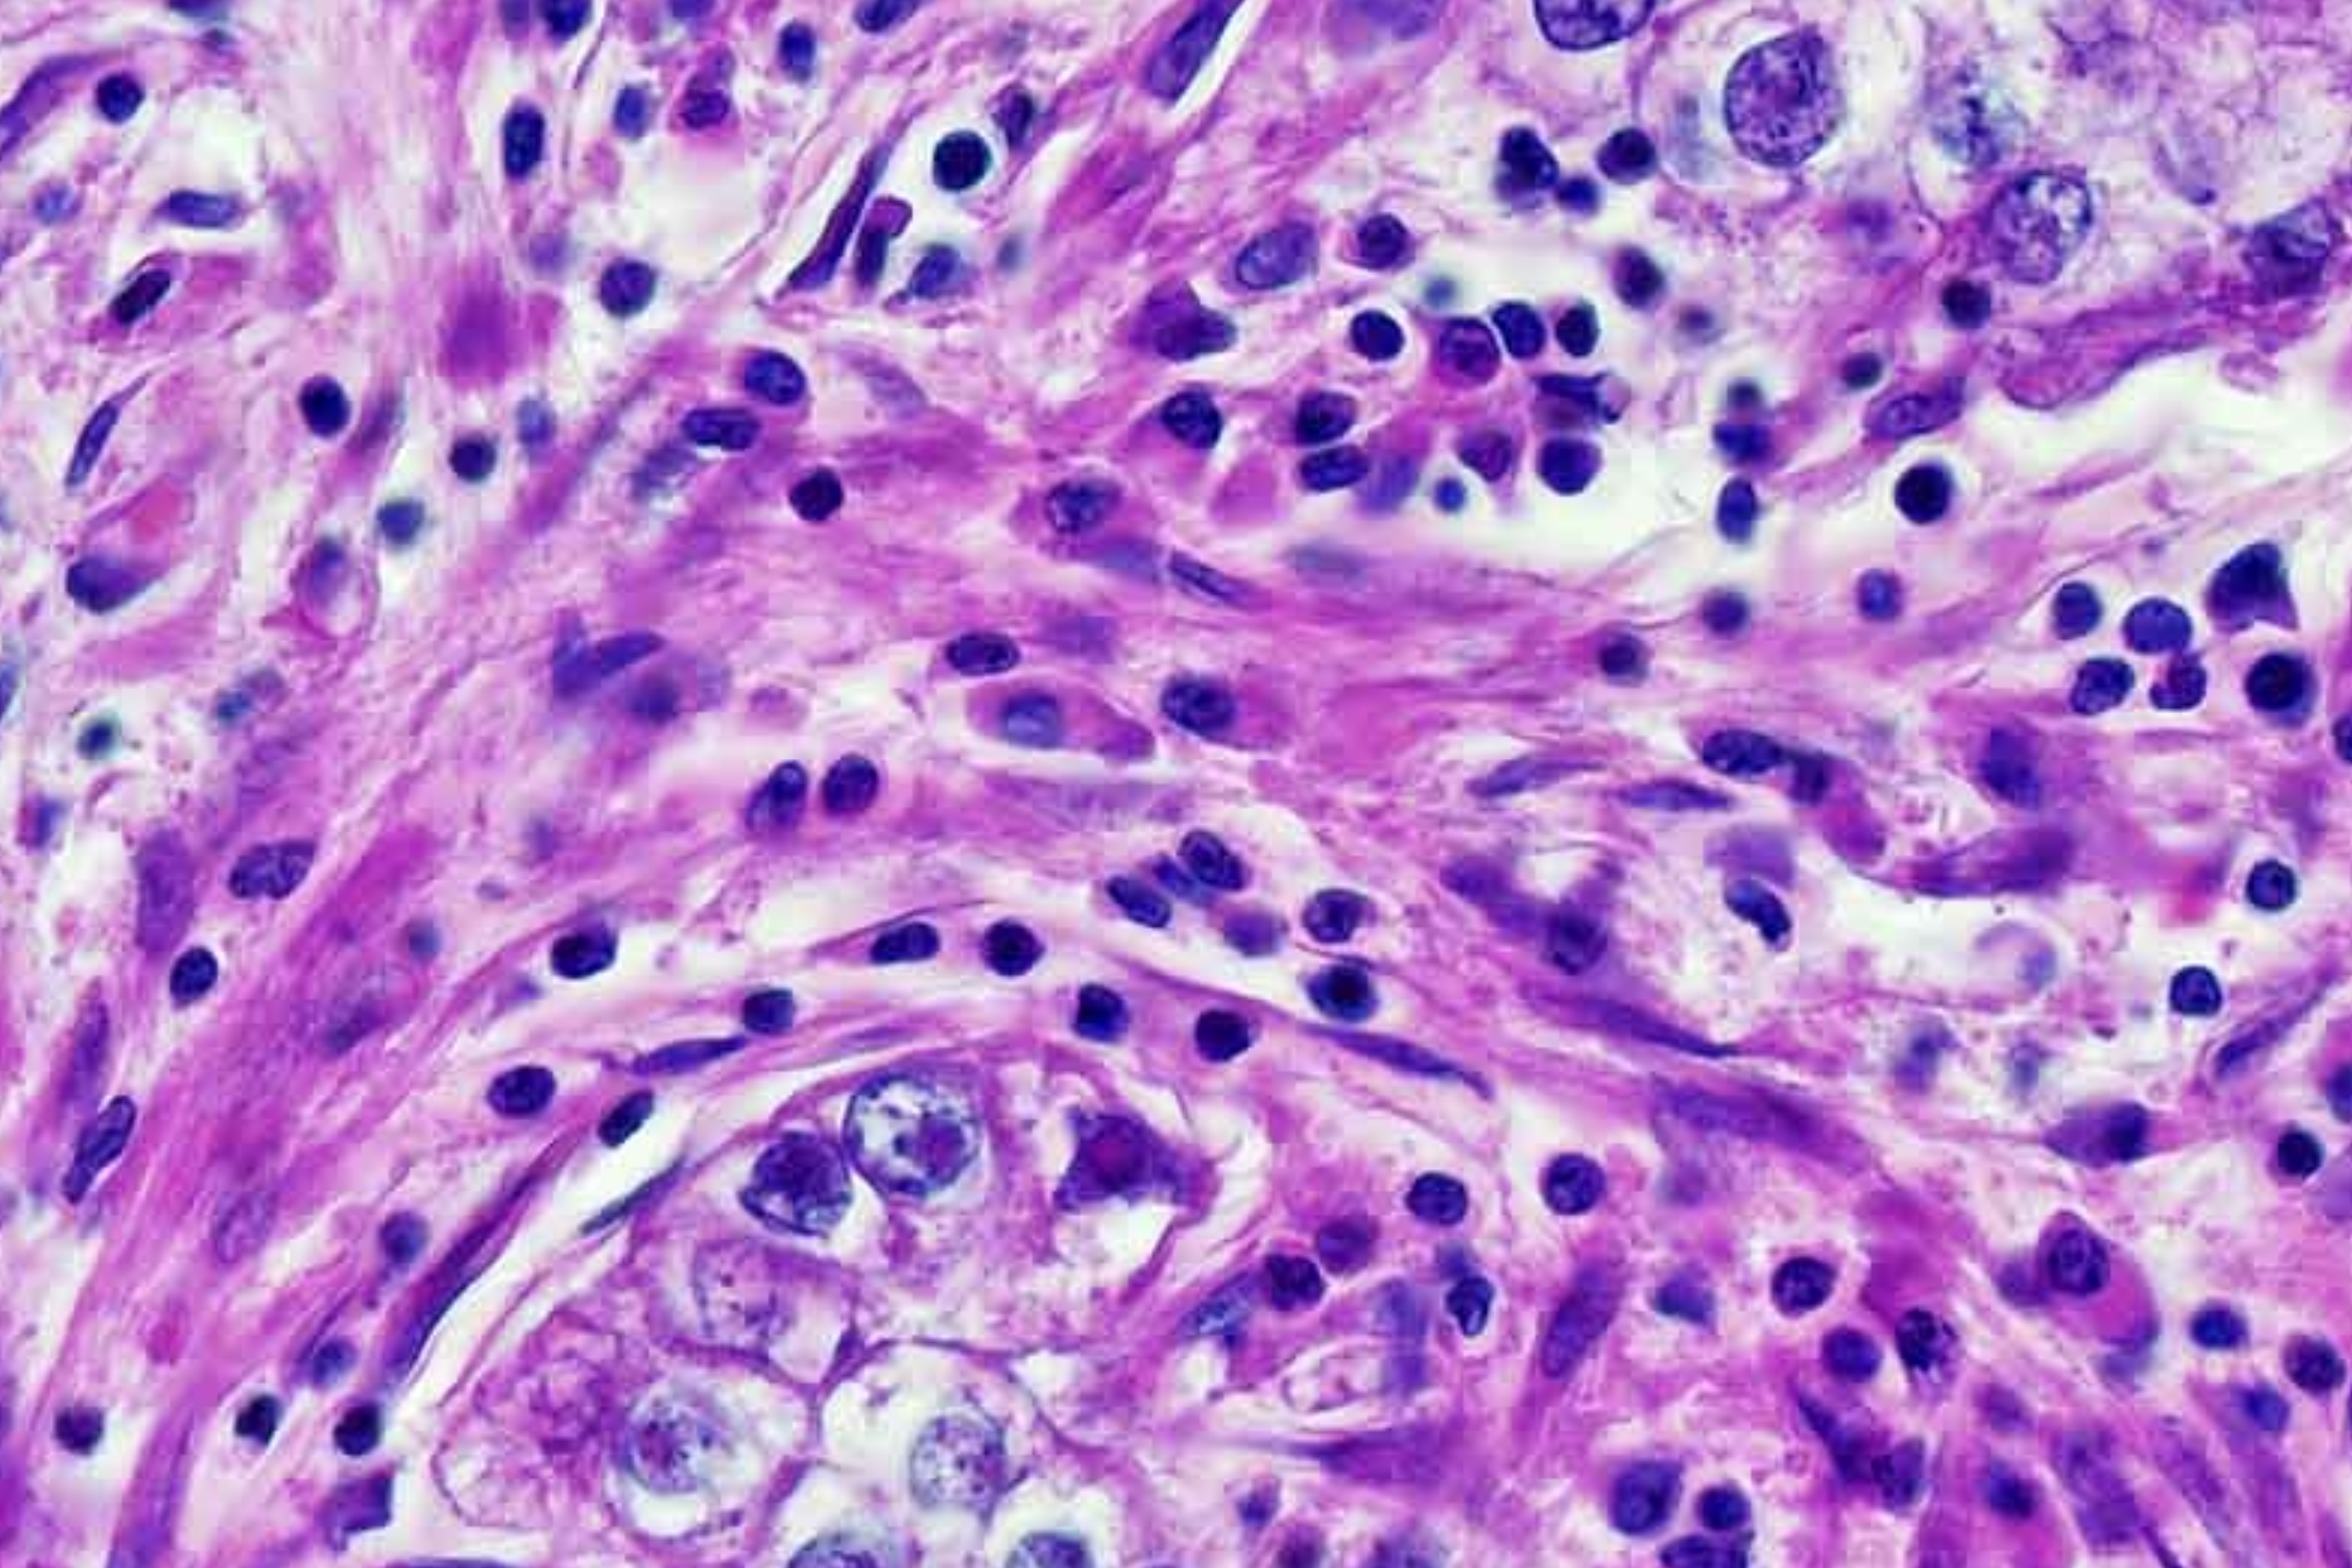

Commercialisation Executive Faculty of Medicine
Conor Simpson is a Commercialisation Executive within Imperial College London’s Faculty of Medicine, working at the interface of academia and industry to assess, protect and commercialise innovations in medical devices, diagnostics, AI for healthcare and pharmaceuticals. His role supports Imperial’s ambition to convert cutting-edge clinical research into real-world impact.
Prior to joining Imperial, Conor served as a Business Developer at Leiden University Medical Centre’s Technology Transfer Office, managing a medical-technology portfolio and negotiating licenses and spin-out agreements. He holds an MSc in Bio-Pharmaceutical Sciences & Business Studies from Leiden University and a BSc (Hons) in Pharmacology from University of Glasgow.
- Email: c.simpson@imperial.ac.uk
/dev01/channel_2/media/images/people-list/Conor-Simpson_Headshot_Imperial-Enterprise_400X400.jpg)


_imperial-tech_3000x2000.png)